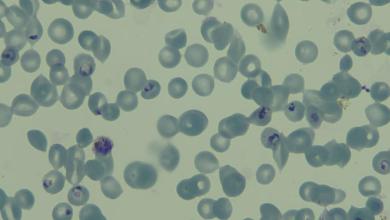
‘This β¦ will be an invaluable resource’ ‘This β¦ will be an invaluable resource’

Driver flips vehicle exiting highway during Wisconsin high-speed pursuit, 2 ejected, 1 dead
CALEDONIA, Wis. (WFRV) β A driver faces numerous felony charges after he sped past a Wisconsin deputy and rolled his vehicle during a high-speed pursuit that left one passenger dead.
According to the Columbia County Sheriffβs Office, deputies stated speed and intoxication were factors in this incident.
Around 3:25 p.m. on February 1, a deputy in a fully marked squad car was on patrol on I-90/94 westbound near the interchange with I-39 in the Town of Caledonia.
A vehicle, also going westbound, allegedly passed the deputy at a βvery high rate of speed.β The deputy attempted a traffic stop, but the driver reportedly failed to pull over and increased its speed to over 100mph while weaving through traffic.
Driver on I-41 in Oconto County loses control, dies after crash into snowplow
Roughly 45 seconds later, the vehicle took the exit ramp to Highway 33. Unable to negotiate the exit ramp due to high speed, the vehicle rolled over, causing two passengers to be ejected from the vehicle. There were reportedly four total occupants of the vehicle.
As first responders were called in, the deputy tried life-saving measures at the scene of the crash.
One of the ejected passengers was pronounced dead at the scene. Two other passengers were taken to local hospitals with life-threatening injuries.
The driver was also hospitalized with serious injuries. Deputies say the 22-year-old driver from Sparta will be facing numerous felony charges.
The investigation into the incident is ongoing.
Copyright 2025 Nexstar Media, Inc. All rights reserved. This material may not be published, broadcast, rewritten, or redistributed.
Source link